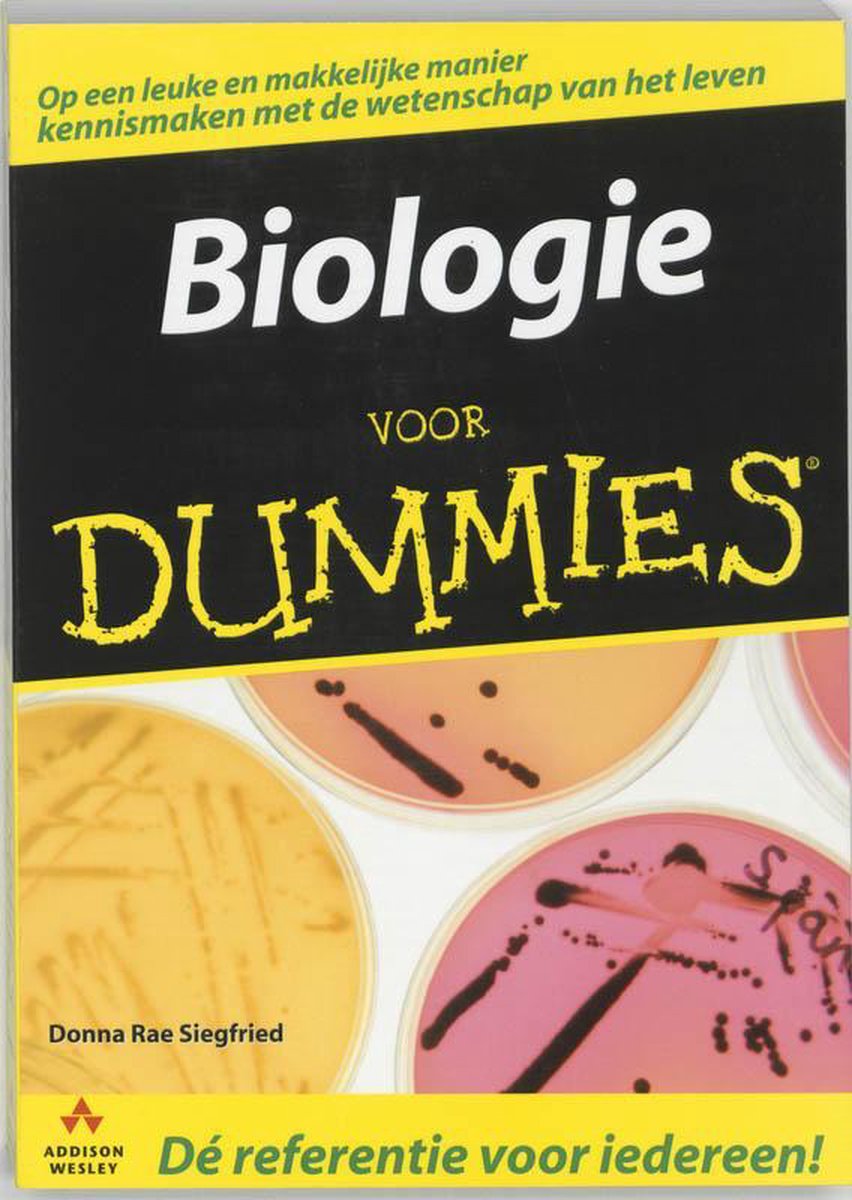

ISBN: 9789043016100
Bekijk boek

Het boek Voor Dummies - Biologie Voor Dummies van de auteur Donna Rae Siegfried is 2 maal gevonden, 0 maal nieuw en 2 maal tweedehands. "Voor Dummies - Biologie Voor Dummies" is tweedehands te koop vanaf € 22,89 bij Bol.com.

|
Aanbieder
Bol.com |
ISBN
9789045351971
Soort boek
Paperback Ben je nieuwsgierig naar het mysterie van het leven? Loop dan met een expert mee door de wereld van de biologie: van cellen, stofwisseling en genetica tot de evolutie, ecosystemen en seks. Met de pocketeditie van Biologie voor Dummies zul je ingewikkelde begrippen uit de biologie razendsnel onder de knie krijgen en alles wat leeft beter leren begrijpen.<br /><br />Donna Rae Siegfried schrijft over farmaceutische en medische onderwerpen in tijdschriften als Runner's World, Men's Health en Organic Gardening. Ook is zij auteur van Het menselijk lichaam voor Dummies.<br />
|
Prijs
€ 22,89 |
Bekijk boek |
|
Aanbieder
Bol.com |
ISBN
9789043010511
Soort boek
Paperback Ben je nieuwsgierig naar het mysterie van het leven? Loop dan met een expert mee door de wereld van de biologie: van cellen, stofwisseling en genetica tot de evolutie, ecosystemen en seks. 'Biologie voor Dummies' staat vol met heldere verklaringen die de geheimen van de biologie onthullen. Je zult ingewikkelde begrippen razendsnel onder de knie krijgen en alles wat leeft beter leren begrijpen.
|
Prijs
€ 37,20 |
Bekijk boek |